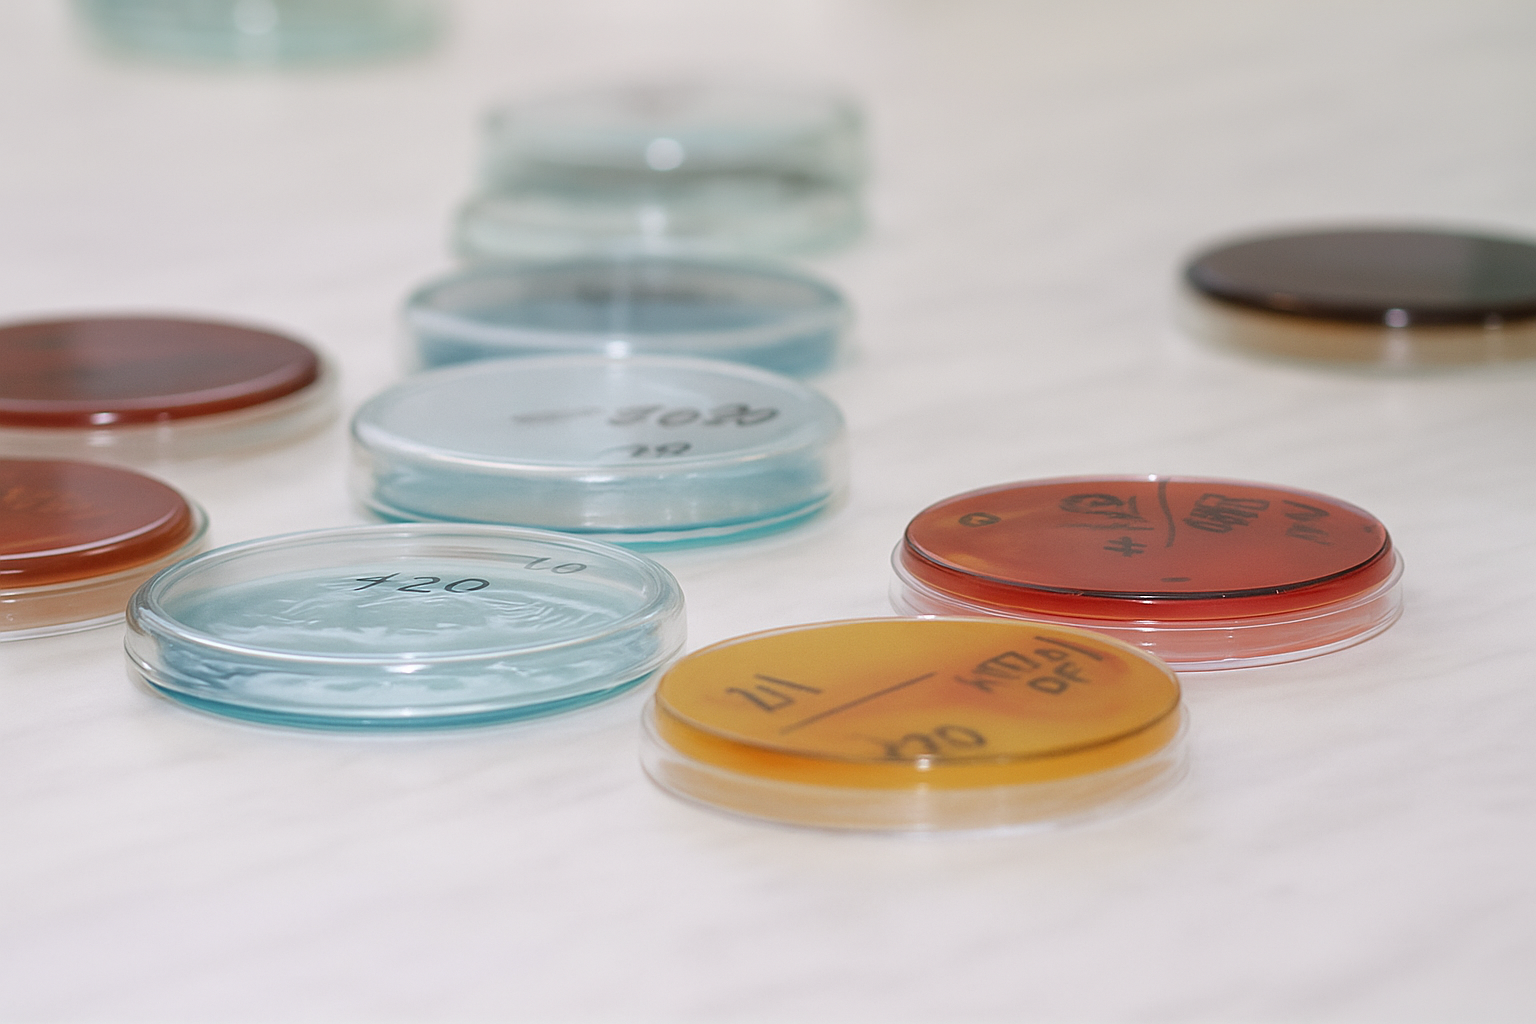
Petriho misky

Činnost oddelenia hygieny potravín
Oddelenie hygieny potravín najmodernejšími postupmi zabezpečuje v oblastiach hygieny potravín (senzorika, mikrobiológia, potravinárska chémia) a v ďalších súvisiacich disciplínach, s využitím moderného prístrojového vybavenia vyšetrovanie potravinárskych komodít so zreteľom na ich zdravotnú nezávadnosť a na dodržanie správnych resp. deklarovaných technologických postupov pri ich výrobe, ďalej sa overuje dodržiavanie výrobných a pracovných postupov ovplyvňujúcich vlastnosti produktov ako je trvanlivosť a pod., kontroluje sa dodržiavanie hygieny a asanácie v prevádzkach a pomáhajú sa objasniť príčiny zistených závad z hľadiska hygienickej akosti živočíšnych produktov.
a potravinový ústav Bratislava
Oddelenie vykonáva:
- komplexné senzorické analýzy
- komplexné mikrobiologické a mykologické skúšky a analýzy potravín živočíšneho a rastlinného pôvodu a surovín určených na výrobu potravín v zmysle požiadaviek potravinového kódexu a platnej legislatívy
- skúšky a analýzy na zdravotnú nezávadnosť surovín a hotových výrobkov v rámci systému HACCP
- mikrobiologické analýzy pre pravidelné kontroly procesu hygieny výroby prevádzkovateľov potravinárskych podnikov a kontrolu hygieny na bitúnkoch v súlade s požiadavkami stanovenými Nariadením komisie (ES) č.1441/2007
- mikrobiologické analýzy pre pravidelné kontroly procesu hygieny výroby v súlade s požiadavkami stanovenými Nariadením komisie (ES) č.2076/2005 pre podniky vyrábajúcich mleté mäso,mäsové polotovary,mechanicky separované mäso a Nariadením komisie (ES) č.1441/2007
- vyšetrenia spojené s uvádzaním potravín do obchodného reťazca, overovanie trvanlivosti, predĺženia doby spotreby
- vyšetrenie sterov z potravinárskych prevádzok na kontrolu účinnosti dezinfekcie, príp. overenie účinnosti používaných dezinfekčných prostriedkov
- vyšetrovanie pôvodcov zoonóz na úrovni Národných referenčných laboratórií (Listeria monocytogenes, Campylobacter jejuni, Yersinia enterotolitica, Staphylococcus aureus a stafylokokový enterotoxín)
- analýzy potrebné pre export a import potravín a surovín
- analýzy podľa požiadaviek zákazníka
- poradenskú a konzultačnú činnosť v oblasti vyvíjania nových potravinárskych výrobkov vrátane označenia potravín podľa platnej legislatívy
Činnosť oddelenia zabezpečuje:
- laboratórium hygieny mäsa a mäsových výrobkov
- senzorické hodnotenie a posúdenie označenia výrobku
- mikrobiologické vyšetrovanie podľa požiadaviek potravinového kódexu a platnej legislatívy
- overenie zhody medzi skutočným a deklarovaným zložením (dôkaz druhových špecifických bielkovín využitím PCR metód a ELISA metód,stanovenie obsahu sóje,falšovanie a autentifikácia mäsových výrobkov,kontrola použitia GMO)
- posudzovanie nových technologií výroby mäsových polotovarov a mäsových výrobkov
- stanovenie rezíduí inhibičných látok
- laboratórium hygieny mlieka a mliečnych výrobkov
- senzorické hodnotenie a posúdenie označenia výrobku
- mikrobiologické vyšetrovanie podľa požiadaviek potravinového kódexu a platnej legislatívy
- overenie zhody medzi skutočným a deklarovaným zložením (dôkaz druhových špecifických bielkovín využitím PCR metód a ELISA metód,falšovanie a autentifikácia mlieka a mliečnych výrobkov)
- posudzovanie nových technologií výroby mliečnych výrobkov
- stanovenie rezíduí inhibičných látok
- laboratórium ostatných potravinárskych produktov (vrátane výrobkov rastlinného pôvodu)
- senzorické hodnotenie a posúdenie označenia výrobku
- mikrobiologické vyšetrovanie podľa požiadaviek potravinového kódexu a platnej legislatívy
- overenie zhody medzi skutočným a deklarovaným zložením (dôkaz druhových špecifických bielkovín využitím PCR metód a ELISA metód,falšovanie a autentifikácia výrobkov, kontrola použitia GMO)
- posudzovanie nových technologií výroby ostatných potravinárskych produktov
- stanovenie rezíduí inhibičných látok (vajcia,med)
Zoznam mikrobiologických skúšok vykonávaných v laboratóriu mikrobiológie:
- stanovenie celkového počtu mikroorganizmov
- stanovenie počtu koliformných baktérií
- stanovenie počtu kvasiniek a plesní
- dôkaz prítomnosti Salmonella spp
- stanovenie počtu koagulázopozitívnych Staphylococcus aureus
- stanovenie počtu Clostrídium perfringenes
- stanovenie počtu mezofilných anaeróbnych spórotvorných mikroorganizmov
- stanovenie počtu Clostrídium perfringens
- stanovenie počtu Bacillus cereus
- stanovenie počtu β-d-glukuronidázopozitívnych Escherichia coli
- dôkaz prítomnosti Escherichia coli O 157(VTEC,verotoxín produkujúce E.coli)
- stanovenie počtu Enterobacteriaceae
- dôkaz prítomnosti Enterobacteriaceae
- dôkaz pritomnosti Enterobacter sakazakii(dojčenská výživa)
- stanovenie počtu Enterokokov
- stanovenie počtu Lactobacillus sp.
- stanovenie počtu Leuconostoc sp.
- stanovenie počtu osmofilných kvasiniek
- stanovenie počtu psychrofilných mikroorganizmov
- stanovenie počtu Pseudomonas aeruginosa
- stanovenie počtu Listeria monocytogenes
- dôkaz prítomnosti Listeria monocytogenes
- dôkaz prítomnosti Vibrio parahaemolyticus
- dôkaz prítomnosti Campylobacter sp.
- dôkaz prítomnosti Yersinia enterolitica
- dôkaz prítomnosti Proteus sp.
- stanovenie počtu proteolytických mikróbov
- stanovenie počtu lipolytických mikróbov
- sulfitredukujúce klostrídie
- rýchle metódy na stanovenie patogénov Salmonella sp.,Listeria monocytogenes,Campylobacter sp.,E.coli O157 imunofluorescenčnou metódou VIDAS
- termostatová skúška
- jatočné zvieratá podľa požiadaviek Nariadenia Komisie(ES) č.1441/2007:deštruktívna metóda,Salmonella sp.-abrazívna metóda
- stanovenie mikrobiálnej kontaminácie plôch,prevádzkových zariadení a obalov sterovou technikou
Kontakty
Oddelenie hygieny potravín - vedúca oddelenia
MVDr. Lenka Cabanová PhD., telefón: 043/5837164 e-mail,